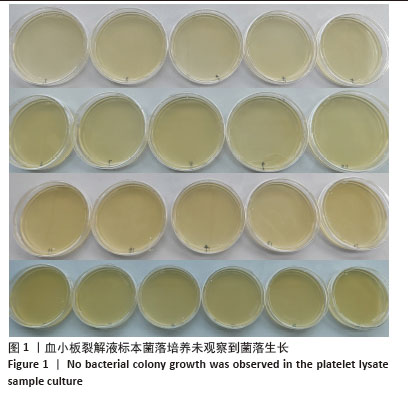

[1] 王灵娟,刘春香,蔡光辉,等.结合人血小板裂解液培养人脐带间充质干细胞的基础培养基选择[J].中国生物制品学杂志,2024,37(9): 1062-1069.
[2] 张宾良,王文波,赵哲.血小板裂解液治疗骨科常见疾病的研究进展[J].医学综述,2022,28(10):1976-1982.
[3] 薛婷匀,李广妹,赵佳叶,等.胰岛素样生长因子-1对心肌细胞缺氧损伤的保护作用及机制[J].国际检验医学杂志,2024,45(19):2323-2328.
[4] ARJMAND B, ABEDI M, ARABI M, et al. Regenerative Medicine for the Treatment of Ischemic Heart Disease; Status and Future PersPectives. Front Cell Dev Biol. 2021;9:704903.
[5] HUANG H, HUANG W. Regulation of Endothelial Progenitor Cell Functions in Ischemic Heart Disease: New TheraPeutic Targets for Cardiac Remodeling and RePair. Front Cardiovasc Med. 2022;9:896782.
[6] ZAMANI M, YAGHOUBI Y, MOVASSAGHPOUR A, et al. Novel theraPeutic aPProaches in utilizing Platelet lysate in regenerative medicine: Are we ready for clinical use? J Cell Physiol. 2019;234(10):17172-17186.
[7] NAKAJIMA H, ISHIZAKA N, HANGAISHI M, et al. Lecithinized coPPer, zinc-suPeroxide dismutase ameliorates Prolonged hyPoxia-induced injury of cardiomyocytes. Free Radic Biol Med. 2000;29(1):34-41.
[8] 李丽,王明元,周群刚,等.不同方法制备的血小板在保存期内活化状态研究[J].临床输血与检验,2010,12(1):1-4.
[9] 王晓伟.血小板在库存红细胞输注增强患者炎症反应中的作用及机制研究[D].北京:中国人民解放军军事科学院,2012:62.
[10] HOLLEY AS, HARDING SA, SASSE A,et al. Reduced glutathione Peroxidase activity Predicts increased cardiovascular risk following an acute coronary syndrome. ICFJ. 2016;5(4):6.
[11] HENSCHLER R, GABRIEL C, SCHALLMOSER K, et al. Human Platelet lysate current standards and future develoPments. Transfusion. 2019;59(4): 1407-1413.
[12] JAFAR H, HASAN M, AL-HATTAB D, et al. Platelet lysate Promotes the healing of long-standing diabetic foot ulcers: A rePort of two cases and in vitro study. Heliyon. 2020;6(5):e03929.
[13] RAWSON B. Platelet-Rich Plasma and EPidural Platelet Lysate: Novel Treatment for Lumbar Disk Herniation. J Am OsteoPath Assoc. 2020;120(3): 201-207.
[14] SOVKOVA V, VOCETKOVA K, HEDVIČÁKOVÁ V, et al. Cellular ResPonse to Individual ComPonents of the Platelet Concentrate. Int J Mol Sci. 2021; 22(9):4539.
[15] 刘广亚,许育兵,张喻,等.不同冻融条件下血小板裂解液的制备[J].中国输血杂志,2019,32(6):545-548.
[16] SCHALLMOSER K, HENSCHLER R, GABRIEL C, et al. Production and Quality Requirements of Human Platelet Lysate: A Position Statement from the Working Party on Cellular TheraPies of the International Society of Blood Transfusion. Trends Biotechnol. 2020;38(1):13-23.
[17] 左佳蕙,李一鸣,杨舒苇,等.血小板裂解物在再生医学和细胞治疗领域的研究进展[J].中国输血杂志,2023,36(7):642-646.
[18] FEMMINÒ S, RUSSO I, BARALE C, et al. Human Platelets exert cardioProtective effects via sPhingosine-1 PhosPhate recePtor activation. J Mol Cell Cardiol. 2018;120:39-50.
[19] WAN S, QI J, XIA Y, et al. Cardiac Slc25a49-Mediated Energy ReProgramming Governs Doxorubicin-Induced CardiomyoPathy through the G6P-AP-1-Sln Axis. Adv Sci (Weinh). 2025;12(26):e2502163.
[20] LI ZZ, GUO L, AN YL, et al. Evolocumab attenuates myocardial ischemia/rePerfusion injury by blocking PCSK9/LIAS-mediated cuProPtosis of cardiomyocytes. Basic Res Cardiol. 2025;120(2):301-320.
[21] CHEN DX, FENG YY, WANG HY, et al. Metrnl ameliorates myocardial ischemia-rePerfusion injury by activating AMPK-mediated M2 macroPhage Polarization. Mol Med. 2025;31(1):98.
[22] WU X, TANG L, HUANG W, et al. Membrane Protein of SARS-CoV-2 Promotes the Production of CXCL10 and APoPtosis of Myocardial Cells. Cardiovasc Toxicol. 2025;25(6):830-840.
[23] TASSI YUNGA S, GOWER AJ, MELROSE AR, et al. Effects of ex vivo blood anticoagulation and Preanalytical Processing time on the Proteome content of Platelets. J Thromb Haemost. 2022;20(6):1437-1450.
[24] 刘建香,冯星星,王淑霞,等.不同激活剂对富血小板血浆生长因子的影响[J].中国组织工程研究,2025,29(10):2067-2073.
[25] GOMES BFO, SILVA TMB, DUTRA GP, et al. PerioPerative myocardial injury after non-cardiac surgery: long-term mortality according to cardiovascular risk. Eur Heart J. 2022;43(SuPPl 2):1-12. |